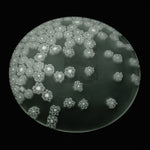
ムラーノガラス(ベネチアングラス)/小皿

Ercole Moretti「HARUKAZE」[Bianco]
日時指定がある場合は、「ADD TO CART」に進み、ご入力ください。その他のご要望がある場合は「Add order notes」にご入力ください。
※ギフトラッピング・熨斗包装無料
- Description
- Attention
- Shipping&Return
小皿「春風」 Bianco
Size:Φ8cm
*
これまでは小花柄をびっしりと敷き詰めたデザインしか存在しなかったムリーネのテーブルウェアでしたが、エルコレ・モレッティ工房の素晴らしいプロジェクトによって全く新しい美しいムリーネのお皿が誕生しました。
ムラーノガラスの伝統技法とスタイリッシュなデザインが見事に融合した一品です。
チョコレートやおひがしはもちろん、小物入れとしてお部屋のインテリア・アイテムとしてもどうぞ。
お手持ちの食器用洗剤で洗えば、油ものや蜂蜜などの粘り気もきれいに落ちますので、ご安心ください。
ヴェネチア・ムラーノ島で伝承される伝統的な技法により、ひとつひとつ職人の手によって、丁寧に作られたガラスです。
そのため、個体差があり、写真とは色や柄の入り方が異なる場合がございます。
吹きガラスにおいては、制作途中に発生する小さな気泡や黒点、底面にポンテ跡(吹き竿を外した際の凹凸)がある場合がございます。
ご了承の上お買い求めください。
・
■ガラス製品のお取り扱いについて
・耐熱ガラスではございません。熱いお飲物等を入れてのご使用はお控え下さい。
・食器洗浄機・電子レンジ等のご使用はお避け下さい。
・金属たわし・クレンザーの使用は破損等の原因になります。お手入れの際は、柔らかい布、スポンジ、中性洗剤をご使用下さい。
■配送について
【日本国内】
配送料金:一律580円(税込)
配送業者:日本郵便
【海外配送】
配送料金:一律3,000円(税込)
配送業者:Fedex
■お引き渡し時期
ご注文後、5営業日以内(火・水曜日定休)に発送いたします。日時指定がある場合はカート画面よりご指定が可能です。
※自然災害や社会インフラのトラブル等をはじめとする不可抗力により、配送遅延が発生する場合がございます。
■返品・交換について
お客様都合による返品・交換は承っておりません。
製品の不良、弊社ミスによる返品・交換・修理については承ります。
細心の注意を払い検品・梱包を行っておりますが、万一不都合な点がございましたらお手数をおかけ致しますが、Contactフォームよりお問い合わせください。
※商品を撮影し掲載しておりますが、ひとつひとつが手作りのため実際の商品と色合いや模様の入り方が異なる場合があります。この場合は不良として扱いませんので予めご了承ください。
すべての商品は、北参道 chisa にて実際にご覧いただけます。
Ercole Moretti「HARUKAZE」[Bianco]
- Related products
- Recently viewed